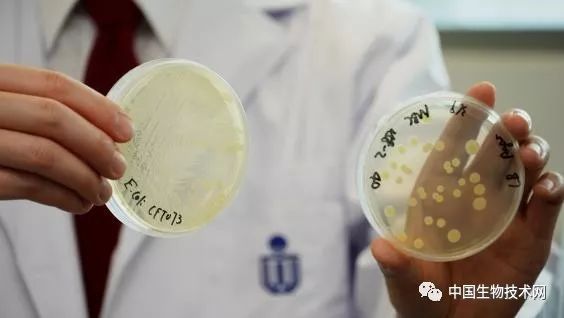

香港科技大学破解大肠杆菌素致癌机制

中国生物技术网诚邀生物领域科学家在我们的平台上,发表和介绍国内外原创的科研成果。
注:国内为原创研究成果或评论、综述,国际为在线发表一个月内的最新成果或综述,字数500字以上,并请提供至少一张图片。投稿者,请将文章发送至weixin@im.ac.cn。
本公众号由中国科学院微生物研究所信息中心承办
微信公众号:中国生物技术网 回复关键词“热点”可阅读热点专题文章,包括“施一公”、“肠道菌群”、“肿瘤”、“免疫”和“健康”
登录查看更多
相关内容
Arxiv
5+阅读 · 2018年1月26日






